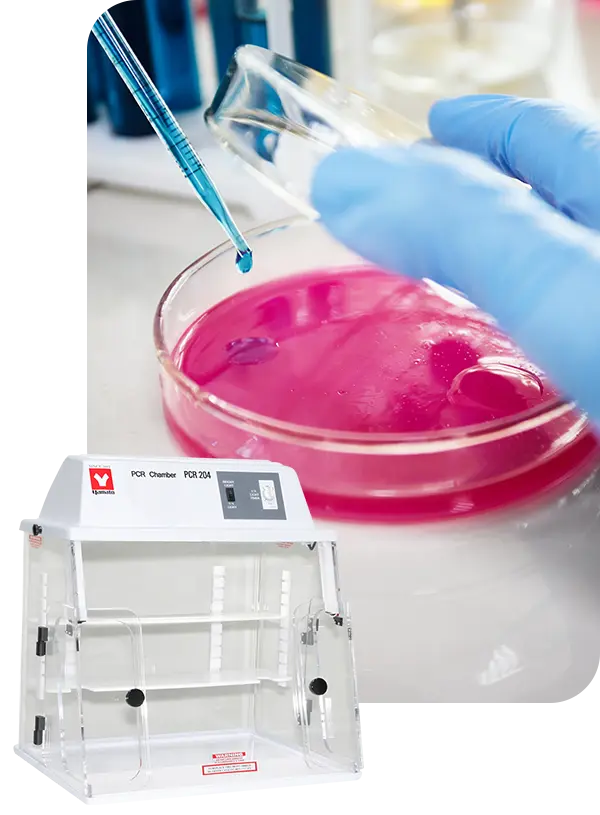
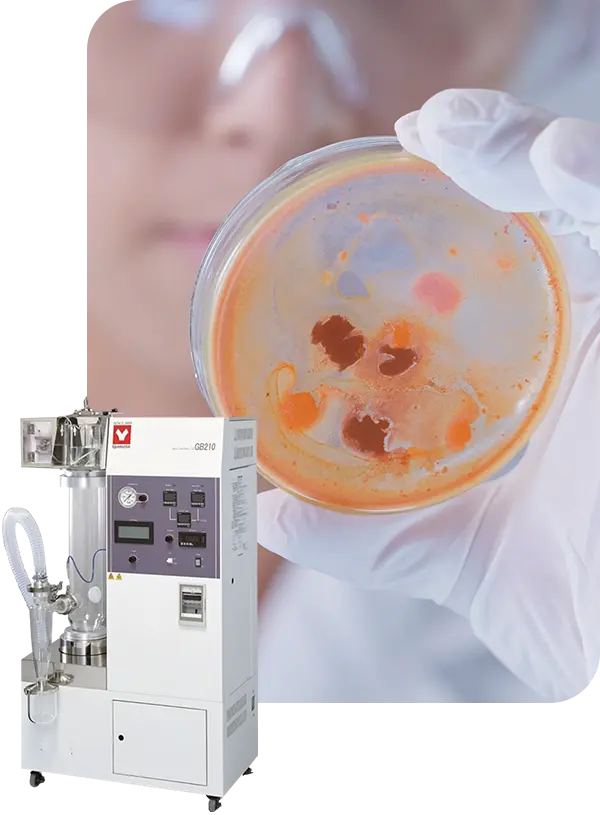

Biology & Microbiology Lab Instruments
Securing the funding you want for your biology or microbiology lab is tough. So you’re thoughtful about every cost you incur. We find gaps in other manufacturers’ microbiology lab instruments and fill them, so every dollar of budget you spend with us returns more to your lab, your colleagues, and your life’s work.
Biology & Microbiology Lab Instruments
Securing the funding you want for your biology or microbiology lab is tough. So you’re thoughtful about every cost you incur. We find gaps in other manufacturers’ microbiology lab instruments and fill them, so every dollar of budget you spend with us returns more to your lab, your colleagues, and your life’s work.
Latest News
Trusted by your colleagues and contemporaries






Trusted by your colleagues and contemporaries






Breeze through the most common challenges in biology and microbiology labs
Breeze through the most common challenges in biology and microbiology labs


Competition for grants and other funding is intense.
When you get your funding, you need to be responsible with it. Future funding depends on how you manage your budget today. Yamato instruments return more value to your biology and microbiology lab, per dollar spent, than any other manufacturer.

Your resources are always going to be fewer than your needs
Money is a resource. Bench space is a resource. Time is a resource. So is the capacity to repair. Your Yamato instruments are crafted to make more of thin resources in your lab. Whether it’s a small footprint, long-life parts, or lower purchase prices on instruments other manufacturers gouge you on, we help you max out your resources.



There aren’t enough hours in the day
Your work takes time and your SOPs are meticulous. So you need to reduce potential time waste. Instrument breakdowns waste your time. Inefficient bench and floorspace waste your time. Overly complicated instruments and micromanaging processes waste your time. Your Yamato instruments are built to optimize your time in every way we can think of.
Why do other biologists and microbiologists trust our instruments?
“When our departmental autoclave was broken. We needed an autoclave that was large enough to handle a 4L flask (this is our largest glassware). Yamato had the largest capacity for the lowest cost, the company has also been around for a while which is important when it comes to reliability. I would buy it again given the opportunity, and I did not realize Yamato had so many offerings so I may buy other types of equipment in the future.”

Jacob Danielson
Research Associate / Lab Manager
University of Toledo Department of Medicine
“I started looking at budget numbers associated with ultrapure water in our lab. The cost was substantial with our existing system - which I won’t name. But you could probably guess what we were using. I did a cost comparison with a few systems and the Yamato came out way ahead of anything else. It wasn’t even close. The large filter cartridges are amazing. And now we save about 40% of the budget we used to spend on type 1 water. These are the only systems I’ll ever purchase now.”

Kingsley Dalley
Lab Manager
“We run PCR for Ebola, and rapid diagnostic tests for malaria in a mobile lab. The containment box is very comfortable to work with, and the viewing area is large and unobstructed. Since we set these labs up rapidly in locations all over the continent, the ability to move the glove box across large distances easily and assemble it in field labs quickly is a significant benefit.”

M. McCall
Clinical Microbiologist & Group Leader
Want help finding the best value for your lab?
Send us some details and a local application expert will help you talk it out.
Get free help choosing your instruments
(no talking required)
How do you know if a portable spectrophotometer is suitable for your application?

Can a plasma
cleaner save your lab money
over the long term?

Most labs are overpaying by up to 50% for the ultrapure (type 1) water they use. Is your lab one of them?
Learn if you are with this free guide.

Frequently asked questions
Do you provide demo instruments?
That depends.
Some of the instruments you need aren’t well suited for the kind of demo you probably want.
We’ll help you figure out the best way to verify/validate your need and the appropriateness of the Yamato solution. Sometimes that means coming up with creative solutions. And we love being creative.
You can contact us to talk more.
My application needs some customization. How long does that take?
The scale of the customization dictates how long it will take. Contact us below or give us a call at 1.800.292.6286 to talk over your parameters and we can give you an accurate estimate.
Do my instruments come with a warranty?
All Yamato instruments come with a 1 year warranty. This covers all products, parts, and materials under normal use.

*based on 3rd party testing vs 4 leading brands (2021)
*based on 3rd party testing vs 4 leading brands (2021)